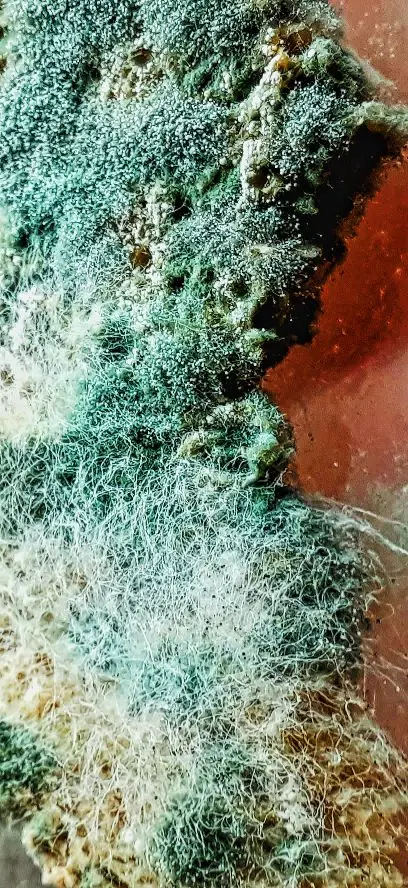

Макрообъектив Ulanzi 17 мм 10X Универсальный для iPhone X XS 11 12 13 Mini Pro Max Samsung S8 S9 S10 S20 S21 Huawei XiaoMi, объектив для телефона 




Последнее обновление: 07.03.2023
Отзывы покупателей
V***r
Страна: RU Color: Macro lens and clip Ships From: Russian Federation Доставка: Seller's Shipping Method - RU 02.12.2020
макролинза пришла целая ,упаковка не мятая, в коробочке с 2 креплениями.Можно использовать на прищепке или крепить к самому телефону.Крепление имеет мягкую прокладку,не будет царапать экран. делала макро плесени. увеличение отличное. к самсунгу а 51 подошло все идеально.
A***r
Страна: RU Color: Macro lens and clip Ships From: Russian Federation Доставка: IML Express 29.01.2021
Отличный девайс! Доставили очень быстро!
G***s
Страна: RU Color: Macro lens and clip Ships From: Russian Federation Доставка: Seller's Shipping Method - RU 29.11.2020
отличная линза, заказ пришёл быстро. Спасибо продавцу .
V***v
Страна: RU Color: Macro lens and clip Ships From: Russian Federation Доставка: Seller's Shipping Method - RU 23.01.2021
Заказал 19.01 в Московской области курьер привёз 22.01. Хорошая штуковина, зубы фотографировать получается на отлично
Покупатель
Страна: RU Color: Macro lens and clip Ships From: China Доставка: Standard Shipping 22.09.2020
получила,на тел подошел, и уже есть первые снимки,спасибо! достаточно тяжёлый объектив,видимо стекло!
V***v
Страна: RU Color: Macro lens and clip Ships From: Russian Federation Доставка: IML Express 18.11.2020
Всё отлично! Пришёл в твердом защитном чехле.Пришёл за 6 дней.
V***c
Страна: RU Color: Macro lens and clip Ships From: Russian Federation Доставка: Seller's Shipping Method - RU 06.01.2021
кайф все отлично
K***k
Страна: RU Color: Macro lens and clip Ships From: China Доставка: Standard Shipping 12.09.2020
Все круто, я довольна
I***r
Страна: ES Color: Macro lens and clip Ships From: France Доставка: GLS_FR 07.01.2021
Item is well packed. Я еще не пробовал.
C***o
Страна: BR Color: Macro lens and clip Ships From: China Доставка: 360Lion Standard Packet 08.01.2021
Лучшие линзы уже куплены в жизни, замечательно!
R***a
Страна: BR Color: Macro lens and clip Ships From: China Доставка: Standard Shipping 09.12.2020
Объектив прибыл до месяца! Идеальная коробка и линзы прекрасно работают!; D
G***e
Страна: CI Color: Macro lens and clip Ships From: China Доставка: Standard Shipping 08.01.2021
Reçu tel que décrit et dans les délais communiqués. Bravo !
A***d
Страна: PK Color: Macro lens and clip Ships From: China Доставка: Standard Shipping 14.12.2020
Заказал 4 ноября и получил 14 декабря. Продукт не поврежден и отлично работает.
N***a
Страна: KE Color: Macro lens and clip Ships From: China Доставка: Standard Shipping 19.10.2020
Отличные линзы. Пользовался им несколько раз. Нужна фокусировка, но когда-то сделано, это хорошо
C***e
Страна: BR Color: Macro lens and clip Ships From: China Доставка: Standard Shipping 13.12.2020
Отлично! Как в описании.
A***h
Страна: SA Color: Macro lens and clip Ships From: China Доставка: Direct 25.10.2020
Хорошо
N***h
Страна: OM Color: Macro lens and clip Ships From: China Доставка: Seller's Shipping Method 28.09.2020
Не подходит для моего телефона Huawei.... Кроме того, все в порядке.
F***r
Страна: CO Color: Macro lens and clip Ships From: China Доставка: Standard Shipping 02.03.2021
Все по описанию и фото
Покупатель
Страна: RU Color: Macro lens and clip Ships From: Russian Federation Доставка: IML Express 28.02.2021
Из плюсов: Доставка курьером за 5 дней. Качественно В хорошем чехле. Из минусов: Для хорошей камеры не рекомендую! ❗Если на телефоне уже есть хороший макро-режим, как на моём Huawei p30 pro, не берите!!! ❗ Сделала фото с объективом и без него. Разница очевидна! На телефон фото гораздо лучше. Для телефона, у которого камера не делает макро-снимки, будет хорошо. И это касается всех объективов. Мне просто не нужно было брать его. Надеялась, что камера будет ещё лучше, но увы. Мне ещё попалась прищепка на которую объектив не прикручивается (что-то с резьбой). За прищепку али мне деньги вернул. Краска в районе резьбы сразу слезла, кстати.
A***a
Страна: PL Color: Macro lens and clip Ships From: China Доставка: Standard Shipping 06.11.2020
Он не фокусируется на моем iphone 11 ..
G***a
Страна: RU Color: Macro lens and clip Ships From: Russian Federation Доставка: Seller's Shipping Method - RU 24.02.2021
Заказала 17.02 линза пришла на почту уже 24.02 . Быстрота меня даже удивила!!!!Качество на 5+.Поверьте, этот товар стоит этих денег. Спасибо!Продолжайте в том же духе. Цена 2047,42! Она этого стоит!
O***a
Страна: RU Color: Macro lens and clip Ships From: Russian Federation Доставка: IML Express 22.02.2021
Объектив супер! отличное макро! только не пойму почему в камере по краям видно розовый засвет от покрытия Лизы объектива. может закружилась надо как то
C***a
Страна: RU Color: Macro lens and clip Ships From: Russian Federation Доставка: IML Express 01.02.2021
Отличное качество! Быстрая доставка! Хорошо справляется со своей задачей
A***h
Страна: RU Color: Macro lens and clip Ships From: Russian Federation Доставка: IML Express 22.02.2021
приехало за 3 дня в мск
K***l
Страна: TR Color: Macro lens and clip Ships From: China Доставка: Standard Shipping 26.02.2021
Красивый продукт. Быстрая зарядка. Большое вам спасибо.
C***s
Страна: CA Color: Macro lens and clip Ships From: China Доставка: Standard Shipping 10.02.2021
Отличный продукт
A***a
Страна: UZ Color: Macro lens and clip Ships From: China Доставка: Seller's Shipping Method 03.02.2021
спасибо!!!!
C***a
Страна: CL Color: Macro lens and clip Ships From: China Доставка: Standard Shipping 21.12.2020
Хороший продукт
F***m
Страна: RU Color: Macro lens and clip Ships From: Russian Federation Доставка: IML Express 25.02.2021
Не рекомендую! Не очень понимаю почему столько положительных отзывов!!! - Большая и тяжёлая это не очень удобно - Качество съёмки спорное, не такое чёткое как хотелось бы, есть с чем сравнивать, брал год назад за 500 рублей (на фото в сравнение) на ней фото более чёткое и линза маленькая удобная, компактная. - Самое обидное, данную лупу брал потому что там есть прищепка, но она оказалась пластиковой и с ужасной резьбой и совсем не держит( Написал в магазин об этой проблеме, ответили сразу и попросили скинуть видео на почту, я так и сделал а продовец взял и пропал, уже две недели не отвечает ( Придется открывать спор( (В ноборе есть другое крепление металлическое, но оно не подходит из-за того что я использую чехол на телефоне) + Единственное неплохое в этой лупе это размытие на фотографии заднего фона. + Доставка за 4 дня в Москве - Цена, есть другие аналоги и они дешевле и более четкую картинку дают( Не очень удачная покупка на али, планирую подарит ее а себе что-то другое возьму,
E***a
Страна: IL Color: Macro lens and clip Ships From: China Доставка: Standard Shipping 02.02.2021
Размытый